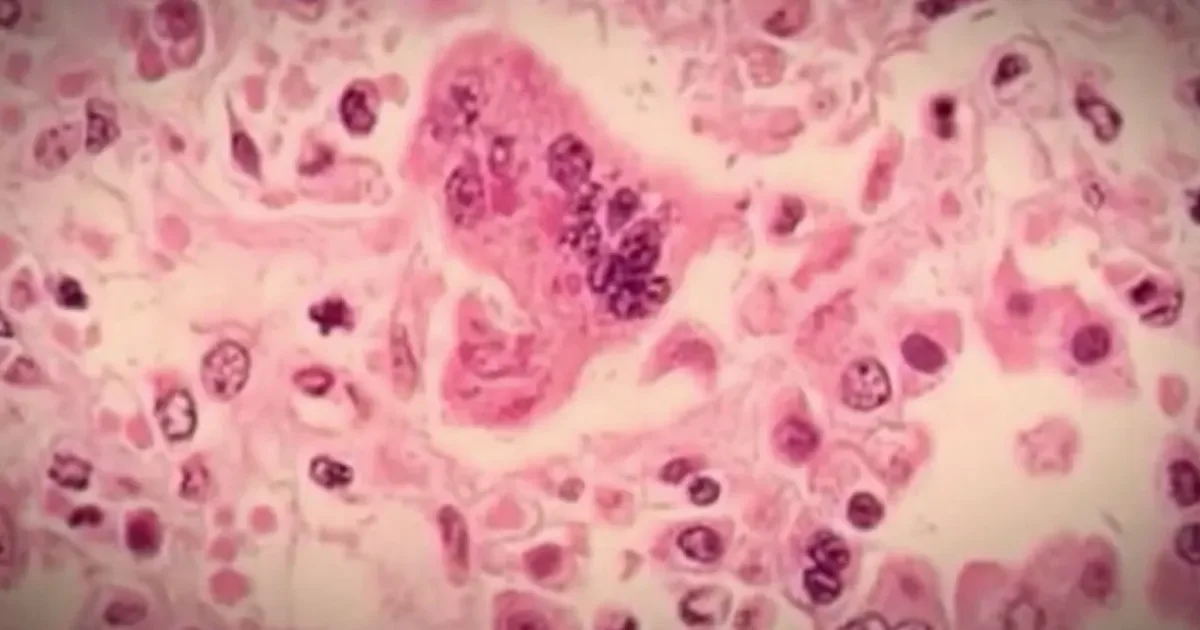
Minnesota weighs ending conscientious-objector exemption for MMR amid measles surge

Minnesota weighs ending conscientious-objector exemption for MMR amid measles surge
Minnesota lawmakers are weighing a bill to remove the conscientious-objector exemption for the MMR vaccine for children in childcare through high school, as a measles outbreak climbs (thousands of cases and hundreds of hospitalizations). The bill would require vaccination unless medically exempt, with Republicans arguing for parental choice, while supporters emphasize the need for high vaccination coverage. A proposed Vaccine Council would advise on who should be vaccinated and when, potentially countering certain federal recommendations.
